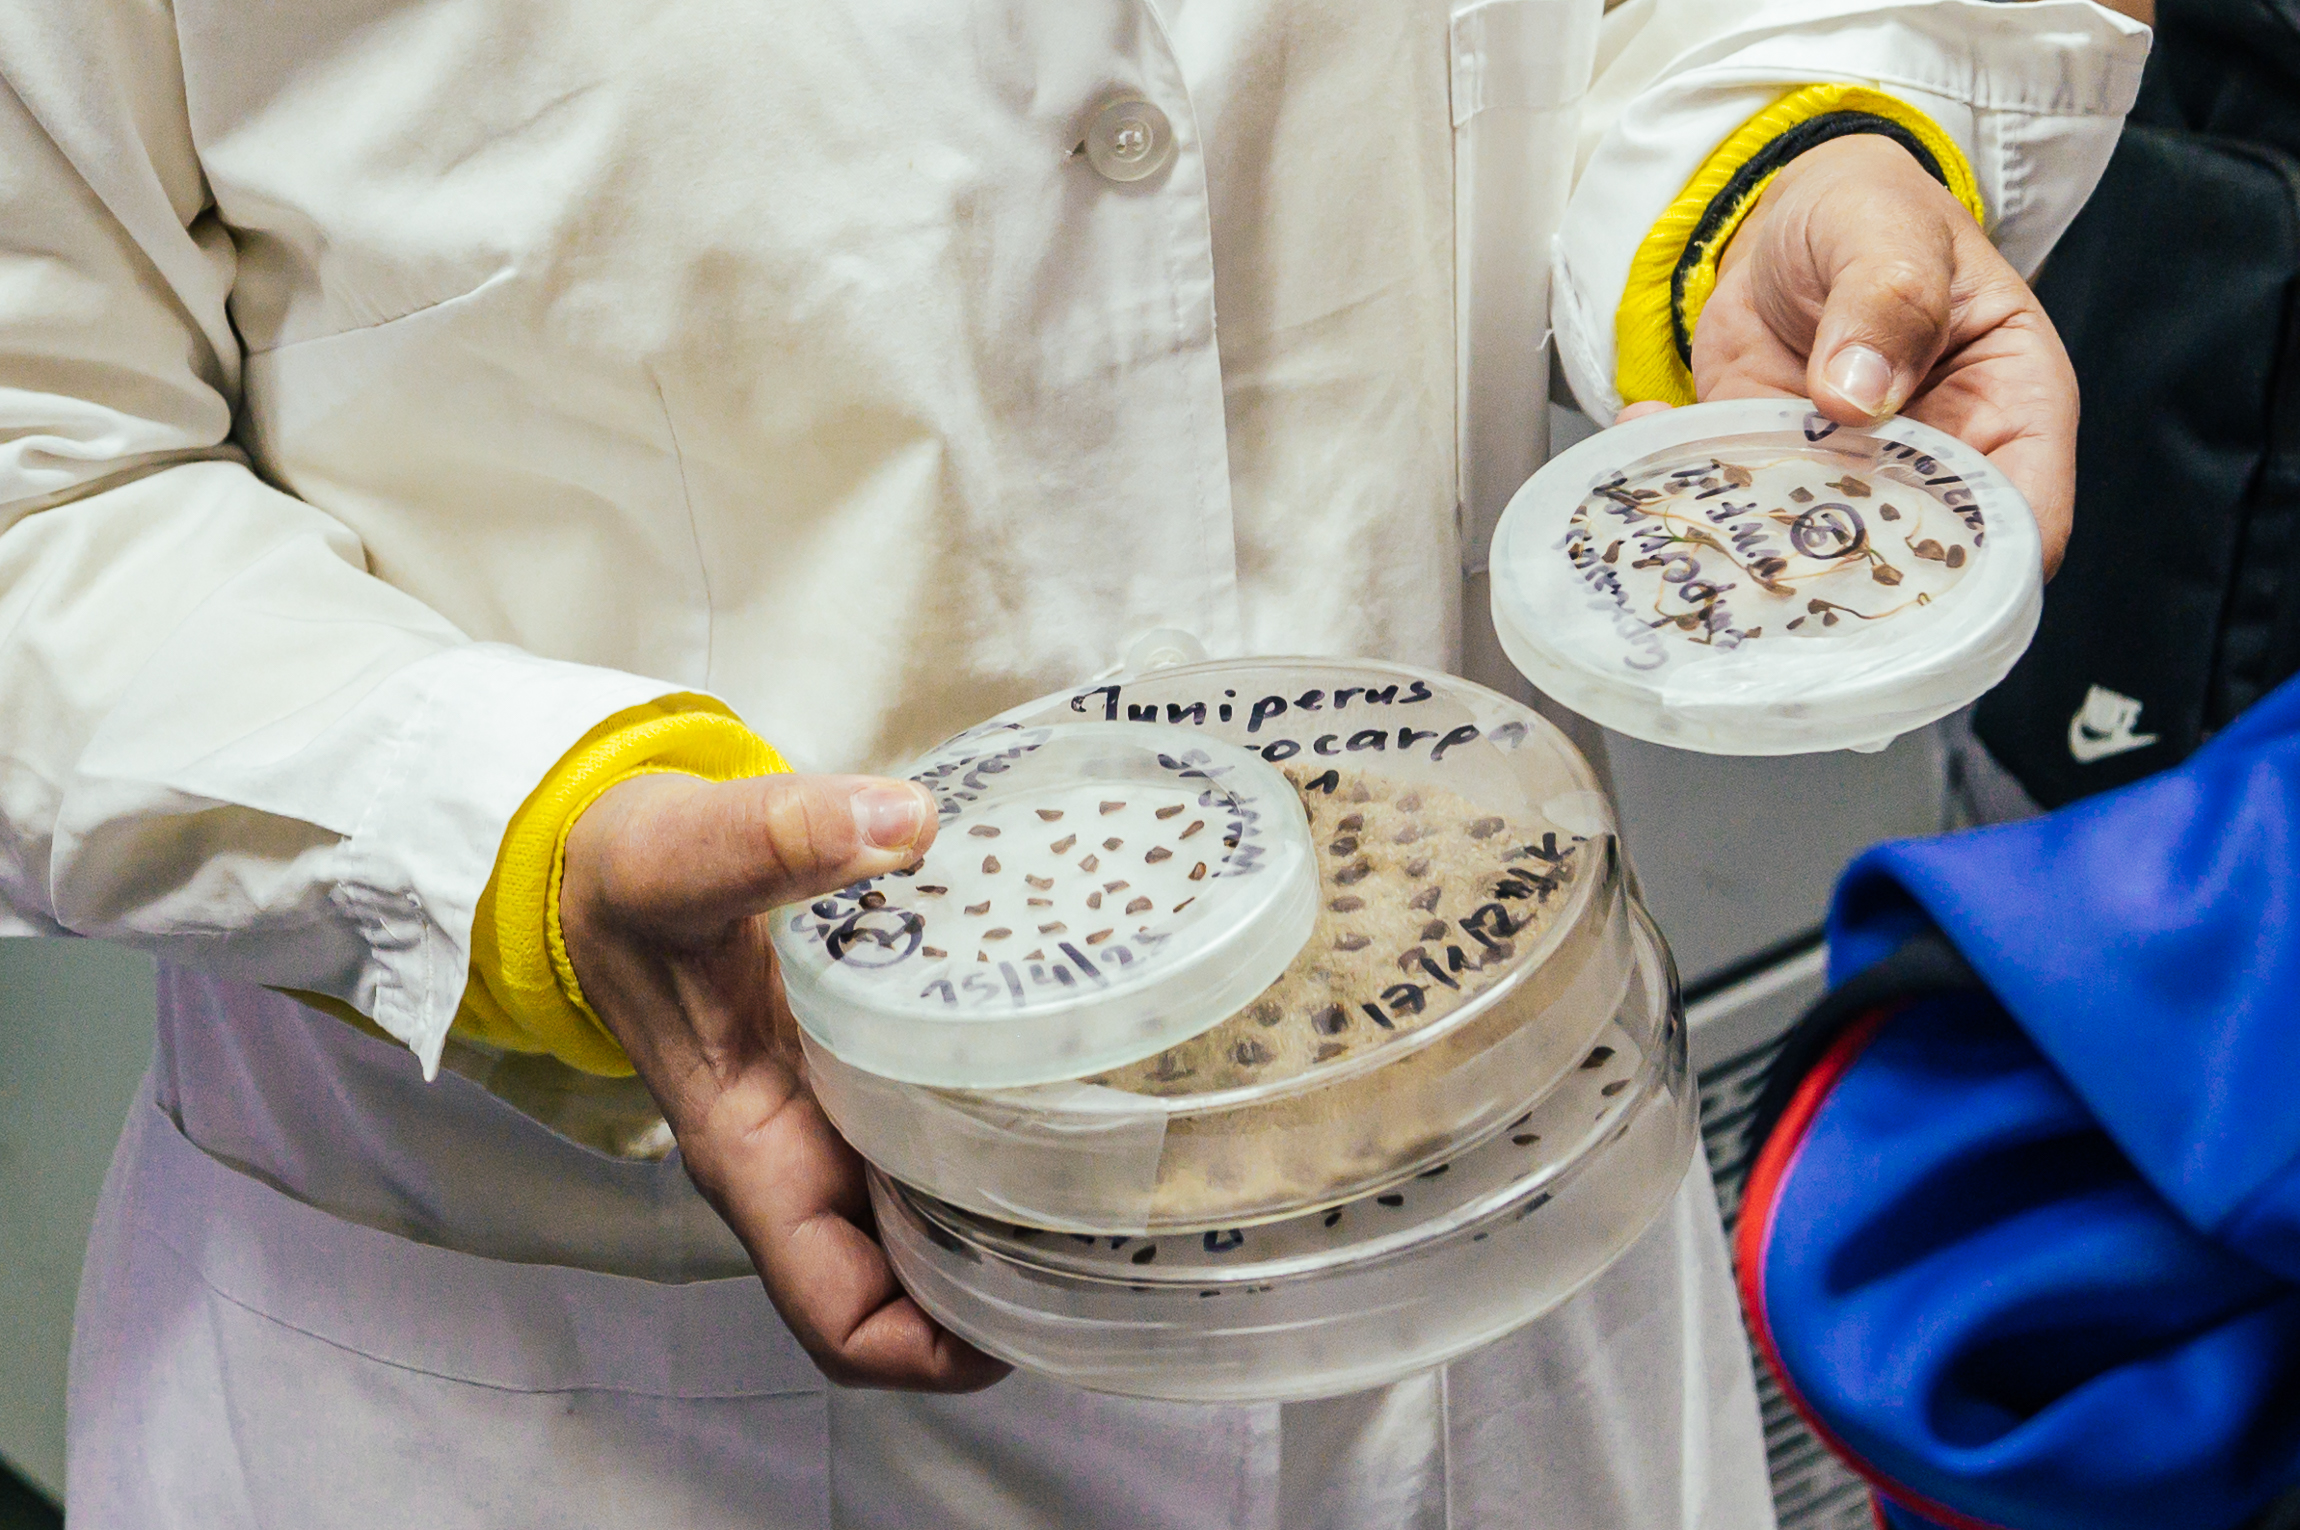

«Ο άνθρωπος είναι κύριος του πεπρωμένου του και το πεπρωμένο του είναι η γη, που ο ίδιος την καταστρέφει μέχρι να μην του μείνει πια άλλο πεπρωμένο», είχε πει πολύ εύστοχα η γεμάτη από χρώματα και λουλούδια ζωγράφος-σύμβολο, Φρίντα Κάλο. Και η Παγκόσμια Ημέρα Περιβάλλοντος είναι μία μέρα και μία ευκαιρία να στρέψουμε το ενδιαφέρον μας σε ό,τι μας περιβάλλει γύρω μας, στο μέρος που «πατάμε» και όπως δείχνουν τα δεδομένα και οι αριθμοί, όπως και τα αποτελέσματα της κλιματικής αλλαγής, καταπατάμε. Στη Γη που θα ήταν καλό να την αντιληφθούμε ως μέρος φιλοξενίας, στην οποία η ευγένεια και ο σεβασμός έπρεπε να είναι πρώτο μέλημα στους κανόνες της συμπεριφοράς μας. Η κορυφαία Βρετανίδα πρωτευοντολόγος, Τζέιν Γκούντολ, με αφορμή τα πανδημικά κύματα, είχε αναφέρει εφιστώντας την προσοχή μας με ξεκάθαρα λόγια: «Αν δεν κάνουμε διαφορετικά τα πράγματα, είμαστε τελειωμένοι. Δεν μπορούμε να συνεχίσουμε για πολύ έτσι».
Γι’ αυτό η Παγκόσμια Ημέρα Περιβάλλοντος είναι μία μόνο, ωστόσο πολύ καλή αφορμή να αναζητήσουμε τρόπους ο καθένας και η καθεμία, από μικρές συνήθειες της καθημερινότητας μέχρι πιο ενεργούς τρόπους να βοηθήσουμε τη φύση να «αναπνεύσει» και να αναγεννηθεί. Μια τέτοια μεγάλη, ξεχωριστής σημασίας κι ενεργή πρωτοβουλία συντελείται περισσότερο από δύο χρόνια στο Δασικό Εκκοκκιστήριο της Αμυγδαλέζας, στο «Κέντρο Επεξεργασίας, Ελέγχου και Πιστοποίησης Δασικού Πολλαπλασιαστικού Υλικού». Αυτός αποτελεί τον μοναδικό προμηθευτή πιστοποιημένων σπόρων για τα δημόσια και ιδιωτικά φυτώρια, είναι με απλά λόγια το μέρος που φυλάσσεται το εθνικό κεφάλαιο, δηλαδή τα δάση και τα φυτά μας.
Η εταιρεία Motor Oil έχει «υιοθετήσει» το δασικό εκκοκκιστήριο της Αμυγδαλέζας και με μηχανήματα σύγχρονης τεχνολογίας έχει καταφέρει να το εκσυγχρονίσει, εξελίσσοντας και μετατρέποντάς το σε Τράπεζα Διατήρησης Δασικού Γενετικού Υλικού. Η υποστήριξη της Motor Oil στο Εκκοκκιστήριο της Αμυγδαλέζας συνεχίζει προστατεύοντας τη φυσική κληρονομιά της χώρας μας διαφυλάσσοντας το περιβάλλον για τις επόμενες γενιές ενώ ο χώρος του έχει και εκπαιδευτική αξία, αφού τον επισκέπτονται μαθητές όλων των ηλικιών και οι εκπαιδευτικοί τους που μαθαίνουν για το Κέντρο και την αποστολή του μέσα από μία βιωματική εμπειρία.
Τι ξεχωριστό συντελείται στο Εκκοκκιστήριο της Αμυγδαλέζας;
«Στην Αμυγδαλέζα οι επισκέπτες αντιλαμβάνονται πόσα λίγα πράγματα γνωρίζουμε για τα δάση και τη σημασία τους», αναφέρει ο Παναγιώτης Παπαδόπουλος, ο εκπαιδευτής, γεωπόνος και ιδρυτής του δικτύου Open Farm. Συνεχίζοντας:
«Η ξενάγηση και η εκπαιδευτική δράση που γίνεται τα τελευταία περισσότερα από δύο χρόνια στην Αμυγδαλέζα κάνει τους επισκέπτες (μικρούς και μεγάλους) να συνειδητοποιήσουν πόσο ευάλωτα είναι τα δασικά μας οικοσυστήματα και πόσο δύσκολη είναι η αναγέννηση τους δάσους έπειτα από μια καταστροφή, όπως η πυρκαγιά. Oι μαθητές ξεναγούνται στο Εκκοκκιστήριο και το Δασικό Φυτώριο, κατανοώντας τη διαδικασία παραγωγής δασικών σπόρων. Κατανοούν τα στάδια συλλογής, διαλογής και την τεράστια σημασία της διατήρησης των δασικών σπόρων… Η αναγέννηση του δάσους από τον σπόρο».
Πάνω από 1.000 επισκέπτες έχει καταγράψει μέχρι στιγμής το «Κέντρο Επεξεργασίας, Ελέγχου και Πιστοποίησης Δασικού Πολλαπλασιαστικού Υλικού», από αυτούς οι +200 επισκέπτες είναι από την πρωτοβάθμια εκπαίδευση, οι +440 επισκέπτες από τη δευτεροβάθμια και +170 επισκέπτες από ειδικά σχολεία & ΕΠΑΛ, καθώς και +120 εκπαιδευτικούς.
Οι μαθητές και οι εκπαιδευτικοί που τους συνοδεύουν πάντα εντυπωσιάζονται, όπως μοιράζονται στο ελc οι γεωπόνοι – εκπαιδευτές, στις επισκέψεις τους από την ξενάγηση στα διάφορα στάδια της παραλαβής, του καθαρισμού, της διαλογής και τους ποιοτικού ελέγχου, που απαιτείται για να μπορέσουν να αποθηκευτούν τελικά λίγα κιλά δασικού σπόρου από τον οποίο θα ξαναγεννηθεί ένα δάσος. Το λεγόμενο «ταξίδι του σπόρου!»
«Δεν γνώριζα ότι ένας σπόρος πρέπει να ελεγχθεί και να διαχωριστεί από τους μη κατάλληλους, ώστε να αποθηκευτεί και να χρησιμοποιηθεί μελλοντικά σε αναδασώσεις», έχουν ακούσει συχνά οι άνθρωποι του Εκκοκκιστηρίου από τους επισκέπτες κατά την ξενάγηση στο δασικό Φυτώριο στην Αμυγδαλέζα. Μαθαίνοντας με τον πιο έμπρακτο τρόπο ότι η διαδικασία αυτή αποτελεί κομβική προσπάθεια για την αναγέννηση και διατήρηση ολόκληρων δασών, αναδεικνύοντας έτσι τη σημασία διατήρησης των σπόρων.
Δάσος θα πει συμβίωση! Θα πει δέντρα, θάμνους, λουλούδια, ζώα, έδαφος, μύκητες, βακτήρια, πεσμένα φύλλα, κορμοί…
Μέσα από το βιωματικό εκπαιδευτικό πρόγραμμα στο «Κέντρο Επεξεργασίας, Ελέγχου και Πιστοποίησης Δασικού Πολλαπλασιαστικού Υλικού» και στο δασικό Φυτώριο στην Αμυγδαλέζα γίνεται έμπρακτη προσπάθεια οι μαθητές να δουν τα δάση από μια διαφορετική οπτική γωνία.
«Το δάσος είναι ένας ενιαίος ζωντανός οργανισμός και όχι απλώς ένα άθροισμα πολλών διαφορετικών μερών. Λειτουργεί μόνο ως σύνολο και βρίσκεται σε απόλυτη ισορροπία», αναφέρει ο Παναγιώτης Παπαδόπουλος. «Ρίχνουμε φως στη βλάστηση του δάσους και μπαίνουμε σε ένα μυστηριώδες και γεμάτο ζωή σύμπαν, προβάλλοντας μια εντελώς καινούρια θεώρηση του δάσους. Τα δέντρα επικοινωνούν μέσω ενός τεράστιου υπόγειου δικτύου μυκητών για να ανταλλάσσουν πληροφορίες και μηνύματα. Τα φυτά ενός δάσους έχουν τη δική τους “σύνδεση στο διαδίκτυο”, που τα βοηθά να παραμένουν σε επαφή και να επικοινωνούν μεταξύ τους (ανεξάρτητα από το είδος)».
Η μυστική ζωή των δέντρων και η ανατροπή από ξεπερασμένες αντιλήψεις
Παράλληλα με τις δράσεις στο δασικό Φυτώριο στην Αμυγδαλέζα, οι επισκέπτες του μαθαίνουν για τη μυστική ζωή των δέντρων, αφού στο εργαστήριο με τους εκπαιδευτές του Open Farm, ανατρέπονται πολλές από τις λάθος ή ξεπερασμένες αντιλήψεις που έχουν ακόμη κι οι μεγάλοι για τον κόσμο τους δάσους…
Τα φώτα όλα πέφτουν πάνω στη βλάστηση του δάσους και οι επισκέπτες έχουν την ευκαιρία να μπουν σε ένα μυστηριώδες και γεμάτο ζωή σύμπαν, προβάλλοντας μια εντελώς καινούρια θεώρηση του δάσους και των φυτών για τον πλανήτη, το περιβάλλον και την υγεία μας.
«…. έχουμε μάθει να κοιτάμε το δέντρο κι ΟΧΙ ΤΟ ΔΑΣΟΣ»
Όπως μοιράζονται οι εκπαιδευτές του Open Farm: πέρα από τα ορατά δέντρα, το δάσος αναδύεται ως ένας εξελιγμένος οργανισμός, που πλημμυρίζει από ποικίλες μορφές ζωής – από τα φυτά, τα ζώα και τα έντομα μέχρι τα μικρόβια που φωλιάζουν στο έδαφος. Αυτές οι διασυνδεδεμένες οντότητες αναπτύσσουν περίπλοκες σχέσεις, και λειτουργούν μέσω της συνεργασίας και επικοινωνίας. Τα δέντρα και τα φυτά συνδέονται μεταξύ τους μέσω ενός υπόγειου δικτύου μυκηλίων, γνωστού ως “Wood Wide Web”. Το δίκτυο επιτρέπει την ανταλλαγή θρεπτικών ουσιών και πληροφοριών, βοηθώντας τα δέντρα να επικοινωνούν και να υποστηρίζουν το ένα το άλλο, διασφαλίζοντας την ευημερία ολόκληρου του οικοσυστήματος. Αυτό το ζωντανό οικοσύστημα παίζει καθοριστικό ρόλο στην προώθηση της βιοποικιλότητας, στη διατήρηση υγιούς εδάφους, στη συγκράτηση του νερού και στον μετριασμό των δυσμενών επιπτώσεων της κλιματικής αλλαγής.
Για τη Motor Oil αποτελεί ηθική δέσμευση η διατήρηση και προστασία του φυσικού περιβάλλοντος και της βιοποικιλότητας, συμβάλλοντας ενεργά στην αντιμετώπιση των πολλών προκλήσεων της κλιματικής αλλαγής. Για τον σκοπό αυτό, εφαρμόζεται μια συνολική στρατηγική με προγράμματα και δράσεις για την επίτευξη των τωρινών και των μελλοντικών στόχων της βιώσιμης ανάπτυξης.
Τα δάση αποτελούν, ανάμεσα σε άλλα, και τον φυσικό μηχανισμό αποθήκευσης διοξειδίου του άνθρακα. Στο πλαίσιο αυτό, ο Όμιλος Motor Oil αντιμετωπίζει σφαιρικά τα δασικά οικοσυστήματα, μεριμνώντας για τις διάφορες φάσεις του κύκλου ζωής τους και ενισχύοντας όλα τα επίπεδα οργάνωσης της βιοποικιλότητας.
Γι’ αυτό τον λόγο ο Όμιλος Motor Oil συνεργάζεται με τους αρμόδιους φορείς και την τοπική κοινωνία, πρωτοπορεί στη συνολική προσπάθεια, καινοτομεί με την αξιοποίηση της πλέον σύγχρονης τεχνολογίας ευθυγραμμίζοντας τη στρατηγική του με τους Στόχους Βιώσιμης Ανάπτυξης των Ηνωμένων Εθνών στηρίζοντας την υλοποίηση της Ευρωπαϊκής Πράσινης Συμφωνίας και συγκεκριμένα την προστασία της βιοποικιλότητας και τη φροντίδα του οικοσυστήματος με σκοπό τη βιώσιμη ανάπτυξη.
Η στήριξη και η αναβάθμιση του Εκκοκκιστηρίου και του Φυτωρίου στην Αμυγδαλέζα Αττικής συνεχώς ενδυναμώνεται, ώστε σταθερά και με διάρκεια να συνεχίσει να αποτελεί κορωνίδα της βιωσιμότητας των δασών της χώρας μας.
Εντυπώσεις από τους +1.000 επισκέπτες του «Κέντρου Επεξεργασίας, Ελέγχου και Πιστοποίησης Δασικού Πολλαπλασιαστικού Υλικού»
Πολύ θετικά είναι τα σχόλια από τους +1.000 επισκέπτες του «Κέντρου Επεξεργασίας, Ελέγχου και Πιστοποίησης Δασικού Πολλαπλασιαστικού Υλικού», από μικρούς και μεγάλους, καθώς είναι μια διαφορετική εκδρομή που τους ανοίγει μια νέα πόρτα για την κατανόηση του φυσικού περιβάλλοντος. Με νέες πληροφορίες για τα δασικά οικοσυστήματα, την κατανόηση μιας πολύ ενδιαφέρουσας επιστημονικής λειτουργίας που είναι η συλλογή και διατήρηση των σπόρων. Οι επισκέπτες έρχονται σε επαφή με τα επαγγέλματα του δασολόγου και γεωπόνου και ανατρέπεται εντελώς ο τρόπος που βλέπουν τον κόσμο των φυτών και του δάσους… όχι πια υποτιμητικά αλλά με σεβασμό και ενδιαφέρον.
Σε αυτό βοηθάει η ενεργή συμμετοχή των επισκεπτών στο βιωματικό εργαστήριο σποράς φυτεύοντας τον δικό τους σπόρο σε ένα βιοδιασπώμενο γλαστράκι, το οποίο και θα το πάρουν σπίτι ως αναμνηστικό, ενώ η εμπειρία είναι ολιστική με συνέπεια στις αξίες της βιωσιμότητας, αφού και το κέρασμα που ακολουθεί αποτελείται αυστηρά και μόνο από πολύ επιλεγμένα και υγιεινά σνακ (βοτανικά αφεψήματα και μπάρες με μέλι & καρπούς) που επίσης δημιουργεί μια εντελώς εναλλακτική εκδρομή κι εμπειρία με επίκεντρο το περιβάλλον, την ισορροπία και την υγεία μας.
Στο Εκκοκκιστήριο της Αμυγδαλέζας συντελείται κάτι ξεχωριστό, που γεννά ζωή, μαθαίνει ενεργά τον σεβασμό στο περιβάλλον, εκπαιδεύει έμπρακτα τους επισκέπτες να αναθεωρήσουν για τη συμβίωσή μας με τη φύση, να γνωρίσουν το ταξίδι του σπόρου, και να περπατήσουν αλλιώς με μία πλέον καινούργια θεώρηση, αυτή που πολύ εύστοχα είπε ενθουσιασμένη μία μαθήτρια κατά την ξενάγηση:
« Τώρα καταλαβαίνω πως οι σπόροι είναι η αληθινή χρονοκάψουλα της ζωής, καθώς μεταφέρεται από περιοχή σε περιοχή και μπορεί να φυτρώσει μετά από εκατοντάδες χρόνια».